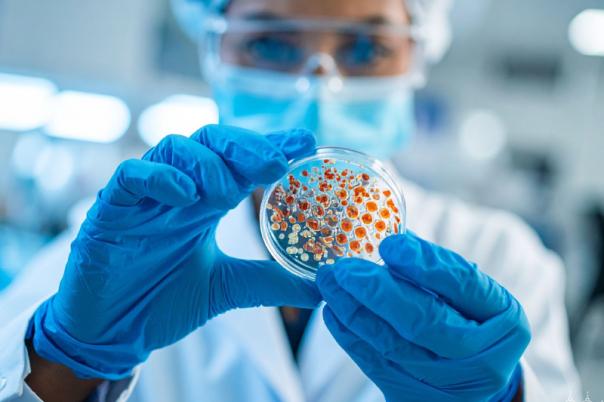
Featured image with circle  (89)

US President Donald Trump and Prime Minister Sir Keir Starmer signed the Tech Prosperity Deal, which sees firms such as Microsoft and Google pledging to spend billions in the UK. The deal focuses on developing the fastest-growing technologies, such as AI, quantum, and nuclear.
The first-ever UK-US tech agreement has been signed with the expectation that it’ll create new healthcare opportunities and drive investment into local businesses and communities both in the US and UK.
With pharma giant AstraZeneca pulling back its expansion plans in the UK as a result of the increasingly challenging environment to conduct business in and the country’s lagging life sciences industry, this agreement could provide the much-needed investment to revamp the UK’s efforts to position itself as a key player in the biopharma space.
AI firms such as Microsoft, NVIDIA, Google, and OpenAI have jointly contributed £31 billion to boost the UK’s AI infrastructure and cutting-edge tech from the data centres to computer chips. Under the partnership, both the US and UK will develop quantum computers and open new doors to use AI in targeted treatments, thus facilitating drug discovery.
Prime Minister Keir Starmer said: “By teaming up with world-class companies from both the UK and US, we’re laying the foundations for a future where together we are world leaders in the technology of tomorrow, creating highly skilled jobs, putting more money in people’s pockets and ensuring this partnership benefits every corner of the United Kingdom.”
This historical pact should speed up world-leading AI research to help develop new therapies, lifesaving treatments, and better cancer care. Both the US and UK have crucial technologies and existing trusted and secure datasets like the UK Biobank at their disposal, which provide the foundations needed to drive AI-powered healthcare solutions.